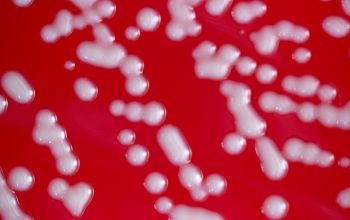

Staphylococcus saprophyticus
-
General information
Taxonomy
Family: Staphylococcaceae
Natural habitats
Isolated from skin and urine samples
Clinical significance
S. saprophyticus is commonly associated with urinary tract infections (UTIs), particularly in young, sexually active women.
It is the second most common cause of uncomplicated UTIs.
While it is generally less virulent than Staphylococcus aureus, it can cause cystitis and, in rare cases, pyelonephritis.
It is usually sensitive to antibiotics like trimethoprim-sulfamethoxazole and nitrofurantoin, though resistance can occur.
Viulence factors, adherence to uroepithelial cells, production of a hemagglutin, production of extracellular slime
-
Gram stain
Gram positive cocci,
0.6-1.4 µm
that occur in irregular grape-like clusters and,
less often, single and in pairs, tetrads, and in short chains.
-
Culture characteristics
-
INFECTION: low numbers of colony-forming units (less than 105 cfu/ml) are often present
Facultative anaerobic
BA: can be intesely yellow at first isolation
Large; entire, very glossy, smooth, opaque, butyrous, convex, non hemolytic; usually white but colonies can be yellow or orange
McConkey: growth (not always)
BBAØ: growth
-
-
Characteristics
-
References
James Versalovic et al.(2011) Manual of Clinical Microbiology 10th Edition
Karen C. Carrol et al (2019) Manual of Clinical Microbiology, 12th Edition